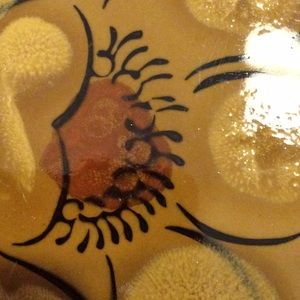

Vintage (1970s) International Stoneware Japan Calypso S296 dinner plate/platter.
C$72
Discounted Shipping
Size
Like and save for later
Add To Bundle
Vintage 1970s International Stoneware Japan Calypso S296 chop plate/service platter.
Excellent Condition
Shipping/Discount

awin101
likes this
Trending Now
Find Similar Listings
Account is under Review
Comment posting is temporarily restricted. Our team will reach out to you shortly. To understand why, select
Learn More.